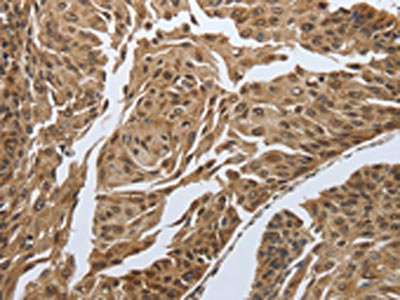

MYH11 Antibody
-
中文名稱:MYH11兔多克隆抗體
-
貨號:CSB-PA082688
-
規格:¥1100
-
圖片:
-
The image on the left is immunohistochemistry of paraffin-embedded Human cervical cancer tissue using CSB-PA082688(MYH11 Antibody) at dilution 1/20, on the right is treated with synthetic peptide. (Original magnification: ×200)
-
The image on the left is immunohistochemistry of paraffin-embedded Human lung cancer tissue using CSB-PA082688(MYH11 Antibody) at dilution 1/20, on the right is treated with synthetic peptide. (Original magnification: ×200)
-
-
其他:
產品詳情
-
Uniprot No.:
-
基因名:
-
別名:AAT4 antibody; DKFZp686D10126 antibody; DKFZp686D19237 antibody; FAA4 antibody; FLJ35232 antibody; MGC126726 antibody; MGC32963 antibody; MYH 11 antibody; MYH11 antibody; MYH11_HUMAN antibody; Myosin 11 antibody; Myosin heavy chain 11 antibody; Myosin heavy chain 11 smooth muscle antibody; Myosin heavy chain antibody; Myosin heavy chain smooth muscle isoform antibody; Myosin heavy polypeptide 11 smooth muscle antibody; Myosin-11 antibody; SMHC antibody; SMMHC antibody; smooth muscle isoform antibody; Smooth muscle myosin heavy chain 11 isoform SM2 antibody; Smooth muscle myosin heavy chain isoform SM2 antibody
-
宿主:Rabbit
-
反應種屬:Human,Mouse,Rat
-
免疫原:Synthetic peptide of Human MYH11
-
免疫原種屬:Homo sapiens (Human)
-
標記方式:Non-conjugated
-
抗體亞型:IgG
-
純化方式:Antigen affinity purification
-
濃度:It differs from different batches. Please contact us to confirm it.
-
保存緩沖液:-20°C, pH7.4 PBS, 0.05% NaN3, 40% Glycerol
-
產品提供形式:Liquid
-
應用范圍:ELISA,IHC
-
推薦稀釋比:
Application Recommended Dilution ELISA 1:1000-1:5000 IHC 1:25-1:100 -
Protocols:
-
儲存條件:Upon receipt, store at -20°C or -80°C. Avoid repeated freeze.
-
貨期:Basically, we can dispatch the products out in 1-3 working days after receiving your orders. Delivery time maybe differs from different purchasing way or location, please kindly consult your local distributors for specific delivery time.
-
用途:For Research Use Only. Not for use in diagnostic or therapeutic procedures.
相關產品
靶點詳情
-
功能:Muscle contraction.
-
基因功能參考文獻:
- the presented study demonstrates that CBFB-MYH11-based MRD status during the first 3 months after allo-HCT, but not KIT mutations, can be used to identify patients with a high risk of relapse. PMID: 27650511
- In patients with MYH11 or ACTA2 variants, the effect of intronic variants on splicing was demonstrated on the mRNA level in the induced smooth muscle cell (SMC), allowing classification into pathogenic or nonpathogenic variants. PMID: 28074631
- Deletion mutation in MYH11 gene causing familial Thoracic aortic dissection was identified in two independent Japanese pedigrees. PMID: 26056961
- Data suggest that expression of MYH11, myosin light chain, and MLCK (myosin-light-chain kinase), is up-regulated in uterine myoma as compared to adjacent smooth muscle cells; expression of MYH11 appears to be involved in cell proliferation. PMID: 25181625
- In familial AAA we found one pathogenic and segregating variant (COL3A1 p.Arg491X), one likely pathogenic and segregating (MYH11 p.Arg254Cys), and fifteen VUS. PMID: 26017485
- CBFB contributes to the transcriptional regulation of ribosomal gene expression and provide further understanding of the epigenetic role of CBFB-SMMHC in proliferation and maintenance of the leukemic phenotype. PMID: 25079347
- we report a novel hypomethylation pattern, specific to CBFB-MYH11 fusion resulting from inv(16) rearrangement in acute myeloid leukemia the expression of which correlated with PBX3 differential methylation PMID: 25266220
- overexpression of MYH11 can lead to increased ER stress and autophagy PMID: 24711452
- MYH11 gene mutation is associated with family history of thoracic aortic aneurysm dissection. PMID: 24921172
- Transcriptional analysis revealed that upon fusion protein knockdown, a small subset of the CBFbeta-MYH11 target genes show increased expression, confirming a role in transcriptional repression PMID: 24002588
- MYH11 mutations are rare and are identified in patients with thoracic aortic aneurysm/dissection. PMID: 21937134
- Incomplete segregation of MYH11 variants with thoracic aortic aneurysms and dissections and patent ductus arteriosus. PMID: 22968129
- We conclude that non-type A CBFB-MYH11 fusion types associate with distinct clinical and genetic features, including lack of KIT mutations, and a unique gene-expression profile in acute myeloid leukemia PMID: 23160462
- Our data indicate that the CBFbeta-SMMHC's C-terminus is essential to induce embryonic hematopoietic defects and leukemogenesis. PMID: 23152542
- A rare variant in MYH11, R247C, alters myosin contractile function and smooth muscle cell phenotype, leading to increased proliferation in vitro and in response to vascular injury. PMID: 22511748
- Data show that homozygous and compound heterozygous changes found in PLOD1 and SLC2A10 may confer autosomal recessive effects, and three MYH11, ACTA2 and COL3A1 heterozygous variants were considered as putative pathogenic gene alterations. PMID: 22001912
- increased MYH11 expression was found in aortic tissues from TAAD patients with 16p13.1 duplications compared with control aortas. PMID: 21698135
- Data show that the purified hMDCs cultured in SMIM for 4 weeks and expressed significant amount of smooth muscle myosin heavy chain and alpha-smooth muscle actin. PMID: 20132408
- Data suggest that that hASMCs contain a significant pool of functional SMM in the 10S conformation that can assemble into filaments upon changing cellular conditions. PMID: 21205888
- CBFB-MYH11 rearrangement is associated with acute myeloid leukemia. PMID: 20508610
- leukemogenic fusion gene (with Cbfb) plays a role in hematopoiesis PMID: 12239155
- Plag1 and Plagl2 are novel leukemia oncogenes that act by expanding hematopoietic progenitors expressing CbF beta-SMMHC. PMID: 15585652
- Human MYH11 gene mutations provide the first example of a direct change in a specific smooth muscle cell protein leading to an inherited arterial diseases PMID: 16444274
- Detection of acute myeloid leukemic cells that are characterized by a CBFB-MYH11 gene fusion. PMID: 16502584
- These observations suggest that when abdominal GS is diagnosed, an analysis of the CBFB/MYH11 fusion gene is necessary to make an appropriate decision regarding treatment options, even if no chromosomal abnormalities are found. PMID: 16504290
- Agents interacting with the outer surface of the CBFbeta-SMMHC ACD that prevent multimerization may be effective as novel therapeutics in AML PMID: 16767164
- Rare fusion transcripts were correlated with an atypical cytomorphology not primarily suggestive for the FAB subtype acute myelocytic leukemia. PMID: 17287858
- Examine consequences of expression of abnormal chimeric protein CBFbeta-MYH11 in acute myelomonocytic leukemia. PMID: 17571080
- MYH11 mutations are likely to be specific to the phenotype of thoracic aortic aneurysms and dissections associated with patent ductus arteriosus and result in a distinct aortic and occlusive vascular pathology potentially driven by IGF-1 and Ang II. PMID: 17666408
- MYH11 gene is involved in only rare instances when persistent patency of the arterial duct occurs in sporadic fashion. PMID: 17956658
- MYH11 mutations in patients with colorectal cancer, Peutz-Jeghers syndrome and juvenile polyposis . PMID: 18391202
- Little evidence for a role of somatic MYH11 mutations in the formation of breast or prostate cancers PMID: 18796164
- three novel amino acid substitutions in MYH11 in AML samples, located in the highly conserved myosin head and rod essential for motor function and regulation of MYH11 PMID: 18798114
- MYH11 mutation is not required for early hereditary nonpolyposis colorectal cancer adenoma formation, but it is selected for in the process of microsattelite instability positive cancer tumorigenesis. PMID: 18941465
- Selective overexpression of airway smooth muscle genes in asthmatic airways leads to increased Vmax, thus contributing to the airway hyperresponsiveness observed in asthma. PMID: 19011151
- sequence deletion in Pseudoxanthoma elasticum PMID: 11439001
顯示更多
收起更多
-
相關疾病:Aortic aneurysm, familial thoracic 4 (AAT4)
-
亞細胞定位:Melanosome. Note=Identified by mass spectrometry in melanosome fractions from stage I to stage IV. Thick filaments of the myofibrils.
-
蛋白家族:TRAFAC class myosin-kinesin ATPase superfamily, Myosin family
-
組織特異性:Smooth muscle; expressed in the umbilical artery, bladder, esophagus and trachea. Isoform 1 is mostly found in slowly contracting tonic muscles.
-
數據庫鏈接:
Most popular with customers
-
YWHAB Recombinant Monoclonal Antibody
Applications: ELISA, WB, IHC, IF, FC
Species Reactivity: Human, Mouse, Rat
-
Phospho-YAP1 (S127) Recombinant Monoclonal Antibody
Applications: ELISA, WB, IHC
Species Reactivity: Human
-
-
-
-
-
-